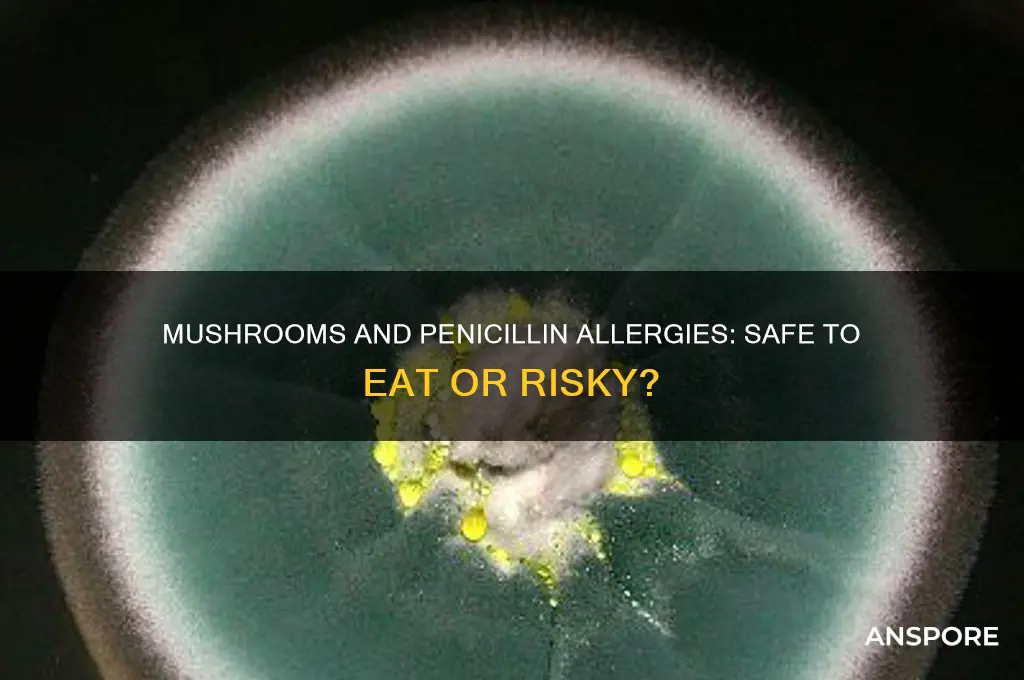
can you eat mushrooms if allergic to penicillin

Many people wonder if they can safely eat mushrooms if they have a penicillin allergy, given that both are derived from fungi. While penicillin is produced by the Penicillium mold, edible mushrooms belong to a different biological kingdom and are not closely related. However, some individuals with penicillin allergies may also react to other fungi or molds due to cross-reactivity, though this is rare. Generally, consuming common mushrooms like button, shiitake, or portobello is considered safe for most penicillin-allergic individuals. If you have a severe penicillin allergy or a history of reactions to fungi, it’s best to consult a healthcare professional before incorporating mushrooms into your diet.
| Characteristics | Values |
|---|---|
| Cross-Reactivity Risk | Generally low. Most penicillin allergies are caused by specific proteins in the antibiotic, not shared by mushrooms. |
| Prevalence of Cross-Reactivity | Studies suggest less than 1% of penicillin-allergic individuals experience reactions to mushrooms. |
| Types of Mushrooms | No specific mushroom types are more likely to cause cross-reactivity. |
| Symptoms of Reaction | If a reaction occurs, symptoms may include itching, hives, swelling, difficulty breathing, nausea, vomiting, or anaphylaxis (rare). |
| Precautionary Measures | Individuals with severe penicillin allergies should consult a doctor before consuming mushrooms. |
| Medical Advice | Always consult a healthcare professional for personalized advice regarding food allergies and potential cross-reactivity. |
Explore related products
What You'll Learn
- Cross-Reactivity Risks: Are mushroom allergies linked to penicillin allergies due to shared proteins
- Types of Mushrooms: Do certain mushroom varieties pose higher risks for penicillin-allergic individuals
- Symptoms to Watch: What allergic reactions might occur if penicillin-allergic people eat mushrooms
- Medical Advice: Should penicillin-allergic individuals avoid mushrooms entirely, or is it safe
- Alternative Fungi: Are there penicillin-safe fungi options for those with allergies

Cross-Reactivity Risks: Are mushroom allergies linked to penicillin allergies due to shared proteins?
Mushroom allergies and penicillin allergies are often discussed in the same breath due to concerns about cross-reactivity. This worry stems from the fact that both mushrooms and penicillin are fungi, leading some to believe they share allergenic proteins. However, scientific evidence suggests this connection is largely a myth. While both belong to the fungal kingdom, the specific proteins in mushrooms and penicillin differ significantly, making cross-reactivity rare. For instance, penicillin allergies are triggered by penicillin-specific proteins, whereas mushroom allergies are typically caused by proteins like hydrophobins or glycoproteins unique to mushrooms.
To assess your risk, consider the following steps. First, consult an allergist for a detailed medical history and allergy testing. Skin prick tests or blood tests can identify specific allergens. If you’re allergic to penicillin, your allergist may recommend avoiding certain types of mushrooms, particularly molds like *Penicillium* species, which are more closely related to penicillin. However, common culinary mushrooms like button, shiitake, or portobello are generally safe unless you have a confirmed mushroom allergy. Second, start with a small portion of mushrooms to test your tolerance, especially if you’re uncertain about your reaction. Monitor for symptoms like itching, swelling, or digestive discomfort.
Despite the rarity of cross-reactivity, exceptions exist. Some individuals with severe penicillin allergies may react to molds or fungi in their environment, including certain mushrooms. For example, *Penicillium* molds, which produce penicillin, can grow on spoiled food or in damp environments. If you’re highly sensitive to penicillin, avoiding such environments and foods may be prudent. Additionally, individuals with a history of multiple allergies or asthma may be at higher risk for cross-reactivity, though this is uncommon. Always err on the side of caution and seek medical advice if unsure.
In practical terms, here’s what you can do. Keep a food diary to track your reactions to mushrooms and other foods. If you experience symptoms after consuming mushrooms, consult your allergist immediately. For those with confirmed penicillin allergies, focus on avoiding penicillin-containing medications and molds rather than mushrooms. However, if you develop symptoms after eating mushrooms, discontinue their consumption and seek testing. Remember, while the risk of cross-reactivity is low, individual sensitivities vary, and personalized medical advice is crucial.
In conclusion, the link between mushroom and penicillin allergies due to shared proteins is minimal. Most people with penicillin allergies can safely enjoy mushrooms without concern. However, exceptions exist, particularly for those with severe penicillin allergies or sensitivities to molds. Always consult a healthcare professional for tailored advice, and take proactive steps to monitor your reactions. By staying informed and cautious, you can navigate dietary choices with confidence.
Canned Straw Mushrooms vs. Fresh White Mushrooms: A Substitute Guide
You may want to see also

Types of Mushrooms: Do certain mushroom varieties pose higher risks for penicillin-allergic individuals?
Mushrooms and penicillin allergies are often discussed in the same breath due to their shared fungal origins, but not all mushrooms are created equal in terms of risk. While penicillin is derived from the *Penicillium* mold, mushrooms belong to a different biological kingdom—fungi. However, some individuals with penicillin allergies may still worry about cross-reactivity. The good news is that most edible mushrooms, such as button, shiitake, and oyster mushrooms, are generally safe for penicillin-allergic individuals. These varieties lack the specific proteins found in penicillin that trigger allergic reactions.
That said, certain mushroom species may warrant caution. For instance, *Reishi* and *Chaga* mushrooms, often used in supplements and teas, contain complex compounds that could theoretically interact with the immune system in unpredictable ways. While there is no direct evidence linking these mushrooms to penicillin allergy cross-reactivity, their immunomodulatory properties suggest a need for prudence. If you’re penicillin-allergic and considering these varieties, start with a small dose (e.g., 1 gram of dried mushroom or 1 teaspoon of tincture) and monitor for symptoms like itching, swelling, or hives.
Another category to approach with care is wild mushrooms, particularly those foraged by non-experts. Misidentification can lead to consuming toxic species, which may exacerbate allergic sensitivities. For example, the *Amanita* genus contains species that can cause severe reactions, unrelated to penicillin but equally dangerous. Always consult a mycologist or use commercially cultivated mushrooms to minimize risk.
For practical guidance, stick to common, well-studied varieties like portobello, cremini, or enoki mushrooms if you’re penicillin-allergic. Avoid experimenting with exotic or medicinal mushrooms without medical advice. Additionally, if you’re pregnant, under 18, or have multiple allergies, consult an allergist before introducing new fungi into your diet. While mushrooms are generally safe, individual sensitivities vary, and caution is always better than regret.
Growing Mushrooms Alongside Garden Plants: Benefits, Tips, and Compatibility
You may want to see also

Symptoms to Watch: What allergic reactions might occur if penicillin-allergic people eat mushrooms?
Penicillin allergies and mushroom consumption are often discussed in tandem due to concerns about cross-reactivity. While mushrooms themselves are not related to penicillin, some individuals with penicillin allergies may experience adverse reactions to certain foods, including mushrooms, due to shared protein structures or immune system sensitivities. Understanding the symptoms of a potential allergic reaction is crucial for those with penicillin allergies who are considering adding mushrooms to their diet.
From an analytical perspective, the immune system's response to allergens can vary widely. In the case of penicillin-allergic individuals, the body may mistakenly identify mushroom proteins as harmful, triggering a release of histamines and other chemicals. This can lead to mild symptoms such as itching, hives, or nasal congestion. For instance, a study published in the *Journal of Allergy and Clinical Immunology* highlights that up to 10% of penicillin-allergic individuals may experience cross-reactive symptoms with certain foods, though mushrooms are not consistently among them. Monitoring for these initial signs is essential, as they can escalate if not addressed promptly.
Instructively, if you suspect a reaction after consuming mushrooms, follow these steps: first, discontinue mushroom intake immediately. Second, take an over-the-counter antihistamine (e.g., 25–50 mg of diphenhydramine for adults) to alleviate mild symptoms. Third, monitor for severe reactions, such as difficulty breathing, swelling of the face or throat, or a rapid heartbeat, which could indicate anaphylaxis. If severe symptoms occur, administer an epinephrine auto-injector (e.g., EpiPen) if available and seek emergency medical attention immediately.
Comparatively, while penicillin allergies are well-documented, mushroom-related reactions in this population are less common but still possible. For example, a case report in *Allergy and Asthma Proceedings* described a penicillin-allergic patient who developed urticaria after consuming shiitake mushrooms, likely due to a shared antigen. This underscores the importance of individualized caution, especially when trying new varieties of mushrooms. Unlike penicillin, which is a direct allergen, mushrooms may act as indirect triggers in sensitive individuals.
Descriptively, severe allergic reactions can manifest rapidly, often within minutes to hours of consumption. Symptoms like wheezing, dizziness, or a drop in blood pressure are red flags. For children or the elderly, who may be more susceptible to severe reactions, vigilance is paramount. Practical tips include starting with a small portion (e.g., 10–20 grams of cooked mushrooms) and waiting 24 hours to observe any delayed reactions. Keeping an allergy diary can also help track patterns and identify potential triggers.
In conclusion, while not all penicillin-allergic individuals will react to mushrooms, the possibility of cross-reactivity or immune sensitivity exists. Recognizing symptoms early—from mild itching to severe anaphylaxis—can prevent complications. Always consult an allergist before reintroducing mushrooms into your diet, especially if you have a history of severe penicillin allergies. With caution and awareness, many can safely enjoy mushrooms without adverse effects.
Can You Plant Morel Mushrooms? A Beginner's Cultivation Guide
You may want to see also
Explore related products

Medical Advice: Should penicillin-allergic individuals avoid mushrooms entirely, or is it safe?
Penicillin allergies affect approximately 10% of the population, often leading individuals to question the safety of consuming mushrooms due to their fungal nature. While penicillin is derived from a fungus, it belongs to a specific class of antibiotics known as beta-lactams. Mushrooms, on the other hand, are part of the Basidiomycota or Ascomycota divisions of fungi, which are taxonomically distinct. This fundamental difference suggests that an allergy to penicillin does not inherently translate to an allergy to mushrooms. However, cross-reactivity remains a concern for some, making it essential to approach this question with caution.
From an analytical perspective, the risk of cross-reactivity between penicillin and mushrooms is extremely low. Studies have shown that penicillin allergies are triggered by specific proteins or beta-lactam structures, neither of which are present in edible mushrooms. For instance, a 2018 review in the *Journal of Allergy and Clinical Immunology* found no evidence of immunologic cross-reactivity between penicillin and common fungi, including those used in food. This data supports the notion that penicillin-allergic individuals can safely consume mushrooms without fear of an allergic reaction. However, individual sensitivities vary, and anecdotal reports of discomfort exist, though these are not supported by clinical evidence.
Instructively, if you are penicillin-allergic and considering adding mushrooms to your diet, start with a small portion to monitor your body’s response. Begin with 10–20 grams of cooked mushrooms (about 1–2 button mushrooms) and observe for symptoms such as itching, swelling, or gastrointestinal distress over the next 24 hours. If no adverse reactions occur, gradually increase the amount in subsequent meals. For children or elderly individuals, who may have heightened sensitivities, halve the initial portion size and consult a healthcare provider beforehand. Always ensure mushrooms are properly identified and sourced from reputable suppliers to avoid toxic varieties.
Persuasively, avoiding mushrooms entirely due to a penicillin allergy is unnecessary and could deprive individuals of their nutritional benefits. Mushrooms are rich in vitamins (such as B and D), minerals (like selenium and potassium), and antioxidants, making them a valuable addition to a balanced diet. The fear of cross-reactivity is largely unfounded, and eliminating mushrooms based on this concern is akin to avoiding all dairy products due to a lactose intolerance—unwarranted and restrictive. Instead, focus on evidence-based precautions and enjoy mushrooms as part of a diverse, healthy diet.
Comparatively, while penicillin and mushrooms both originate from fungi, their biological and chemical compositions differ significantly. Penicillin’s allergenic properties stem from its molecular structure, whereas mushrooms contain proteins, polysaccharides, and other compounds unrelated to penicillin. This distinction is akin to comparing apples and oranges—both fruits, yet distinct in taste, texture, and nutritional profiles. Just as an allergy to one fruit does not imply an allergy to another, a penicillin allergy does not necessitate avoidance of mushrooms. This comparison underscores the importance of relying on scientific evidence rather than assumptions when making dietary decisions.
Using Coco Coir for Mushroom Cultivation: Benefits and Best Practices
You may want to see also

Alternative Fungi: Are there penicillin-safe fungi options for those with allergies?
Penicillin allergies affect approximately 10% of the population, often limiting their exposure to certain medications and foods. But what about mushrooms? While mushrooms are fungi, they are not closely related to penicillin-producing molds, making them a potential safe option for those with penicillin allergies. However, cross-reactivity is a concern, and individual sensitivities vary. For instance, some people with penicillin allergies may also react to certain mushrooms due to shared protein structures, though this is rare.
To navigate this safely, start by consulting an allergist. They can perform skin prick tests or blood tests to assess your specific sensitivities. If cleared, introduce mushrooms in small quantities, such as 1–2 ounces cooked, and monitor for symptoms like itching, swelling, or digestive discomfort. Begin with common varieties like button or cremini mushrooms, which have a lower risk of cross-reactivity compared to exotic types like shiitake or oyster mushrooms. Always cook mushrooms thoroughly, as raw forms may contain allergens that are neutralized by heat.
For those seeking penicillin-safe fungi beyond mushrooms, consider edible varieties like lion’s mane or reishi, often consumed in supplement form. Lion’s mane, for example, is available in capsules (500–1,000 mg daily) or as a tea, and is known for its cognitive benefits. Reishi, typically taken as a tincture (2–5 mL daily) or in powdered form, supports immune health. However, always verify the source and consult a healthcare provider, especially if you have severe allergies or are taking medications.
A comparative analysis reveals that while mushrooms and medicinal fungi are generally safe for penicillin-allergic individuals, caution is key. Unlike penicillin, which is a specific antibiotic derived from *Penicillium* molds, edible fungi belong to different taxonomic groups. For example, mushrooms are part of the Basidiomycota division, while penicillin comes from Ascomycota. This distinction significantly reduces the likelihood of cross-reactivity, but individual responses can still vary.
In conclusion, alternative fungi like mushrooms and medicinal varieties offer promising options for those with penicillin allergies. By taking a cautious, step-by-step approach—consulting experts, starting with small doses, and choosing common varieties—you can safely explore these foods and supplements. Always prioritize safety and personalized advice, ensuring a balanced and informed approach to incorporating fungi into your diet or wellness routine.
Daily Mushroom Consumption: Benefits, Risks, and Nutritional Insights
You may want to see also
Frequently asked questions
Yes, you can generally eat mushrooms if you are allergic to penicillin, as mushrooms are not closely related to penicillin and do not contain the same allergens.
No, mushrooms are fungi, while penicillin is derived from a specific type of mold (Penicillium). They are both fungi but belong to different classifications and do not share the same allergenic properties.
It is highly unlikely, as penicillin allergy is specific to the antibiotic and not to all fungi. However, if you experience symptoms after eating mushrooms, consult a doctor.
No, mushrooms do not contain penicillin or its derivatives. They are a separate type of fungus with different chemical compositions.
Not necessarily. Penicillin allergy is specific to the antibiotic, not to all fungi. However, always consult your healthcare provider if you have concerns about specific foods or substances.

























